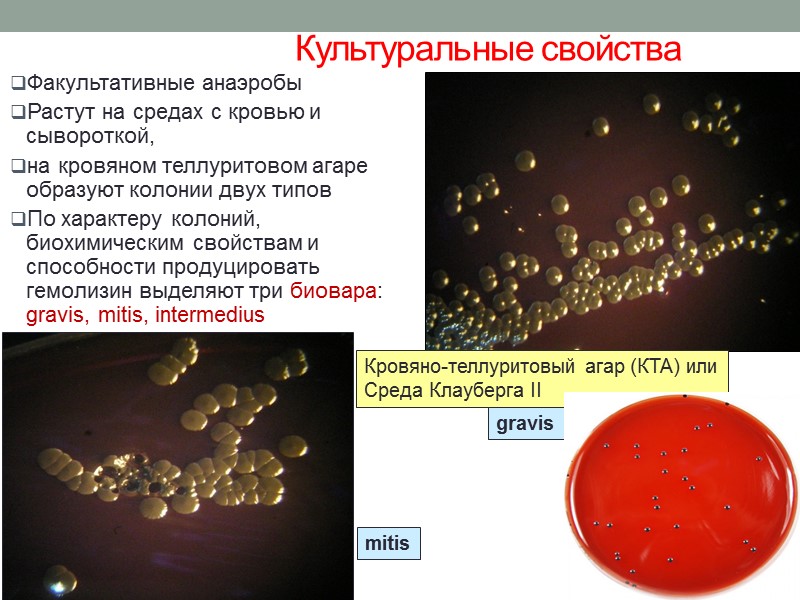
Лабораторная диагностика дифтерии  Клинический материал: мазок из зева, слизь из носоглотки и др.

Дифтерия 1 — острое антропонозное инфекционное заболевание которое


Дифтерия 1 - острое антропонозное инфекционное заболевание которое характеризуется: фибринозным воспалением на месте входных ворот тяжелой интоксикацией организма токсическим поражением сердца, почек и нервной системы Источник инфекции – больной или бактерионоситель токсигенных С.diphtheriae

Морфология C.diphtheriae окраска по Леффлеру Грамположительные палочки с утолщениями на концах, располагаются в виде V неподвижны многослойная клеточная стенка содержит миколовую кислоту, корд-фактор при окраске по Леффлеру и Нейссеру выявляются включения волютина на полюсах клетки C.diphtheriae окраска по Нейссеру C.diphtheriae окраска по Граму

Семейство: Corynebacteriaceae Род Corynebacterium Виды, патогенные для человека: C.diphtheriae (gravis, mitis, intermedius, belfanti) C.ulcerans C.pseudotuberculosis Возбудитель дифтерии - токсигенные C.diphtheriae

Культуральные свойства Факультативные анаэробы Растут на средах с кровью и сывороткой, на кровяном теллуритовом агаре образуют колонии двух типов По характеру колоний, биохимическим свойствам и способности продуцировать гемолизин выделяют три биовара: gravis, mitis, intermedius Кровяно-теллуритовый агар (КТА) или Среда Клауберга II gravis mitis

рост на сывороточном агаре Культуральные свойства 5 рост на кровяном агаре

Биохимические свойства: биохимическая активность невысокая, но позволяет дифференцировать варианты коринебактерий 6 C.diphtheriae ферментирует до образования кислоты ( без газа) глюкозу, галактозу, мальтозу. Не проявляет протеолитическую активность.

Антигены Наиболее изученным антигеном С. diphtheriae является дифтерийный токсин. Термостабильные компоненты клеточной стенки (маннан, поверхностные липиды) обладают групповой специфичностью Термолабильные антигены ( содержат белковую и небелковую фракции) характеризуются внутривидовой (типовой) специфичностью

значительно устойчивы во внешней среде; в дифтерийной пленке, в капельках слюны, на ручках дверей, детских игрушках сохраняются до 15 дней; в пыли, на полу, на предметах в окружении больного дифтерийная палочка сохраняет жизнеспособность до 18-40 дней; в воде выживают в течение 6-20 дней; разрушается под действием обычных дезинфектантов при экспозиции 30 мин; до 600С погибают только через 10 мин; кипячение убивает их моментально. Устойчивость во внешней среде

Факторы патогенности Пили и микрокапсула обеспечивают адгезию к эпителиоцитам миндалин, реже гортани, трахеи, полости носа, конъюнктивы глаза, вульвы; Колонизация эпителиоцитов сопровождается развитием воспалительного процесса, возможно, в этом процессе участвует и дифтерийный токсин пили

Гиалуронидаза, нейраминидаза, коллагеназа, гемолизин – факторы инвазии; микрокапсула – антифагоцитарный фактор; Корд-фактор – нарушает дыхание в митохондриях и обладает антфагоцитарной активностью; Факторы патогенности

Дифтерийный гистотоксин – главный фактор патогенности Гистотоксин состоит из двух субъединиц: токсического полипептида (А) и транспортного полипептида (В), ответственного за доставку токсического компонента к клеткам-«мишеням». Образование первого контролируется бактериальными генами, второго - генами фага, лизогенизировавшего бактериальную клетку; Только лизогенные бактерии, содержащие tox-ген, полученный в результате фаговой конверсии патогенны Фиксация гистотоксина происходит на рецепторах мембран мышечных клеток сердца, паренхимы сердца, почек, надпочечников, нервных ганглиев. В качестве рецептора используется белок для связывания фактора роста; паразит использует жизненно важные структуры клетки хозяина Активация протоксина под действием протеаз хозяина

После проникновения в клетку субъединица А взаимодействует фактором элонгации ЕF-2 и осуществляет его АДФ-рибозилирование. При этом блокируется синтез белка на рибосомах, что, в конечном итоге, приводит к гибели клеток.

Дифтерийный гистотоксин tox ген входит в состав генома бактериофага, и его экпрессия находится под негативным контролем tox репрессора (DtxR), активируемого железом. Когда уровень железа в клетке высок комплекс Fe(ii)-DtxR специфически связывается с tox промотором-оператором (tox PO), предотвращая транскрипцию и, соответственно, синтез токсина. Когда уровень железа снижается и становится лимитирующим фактором, комплекс Fe(ii)-DtxR- tox оператор диссоциирует и начинается транскрипция. Таким образом, синтез токсина происходит в организме хозяина

Патогенез дифтерии После адгезии на клетках слизистой начинается колонизация Под действием гиалуронидазы, нейраминидазы осуществляется разрушение межклеточного вещества, В результате действия гемолизина, корд-фактора и гистотоксина возникают некроз поверхностного эпителия, в результате развития воспалительного процесса повышается проницаемость сосудов, замедляется кровоток, сосуды становятся ломкими. Жидкая часть крови выходит в окружающие ткани. Фибриноген, содержащийся в плазме,при контакте с тромбопластином некротизированного эпителия переходит в фибрин, который выпадает в виде фибринозной пленки.

Патогенез дифтерии В области многослойного плоского эпителия , развивается дифтеритическое воспаление, при котором фибринозный выпот, пронизывая всю слизистую оболочку, плотно спаян с подлежащей тканью. На слизистых оболочках с однослойным эпителием (гортань, трахея, бронхи) развивается крупозное воспаление, при котором пленка легко отделяется. Возбудитель остается в месте входных ворот, а в кровь поступает токсин -токсинемия Наиболее чувствительными к действию токсина являются миокард, капилляры и нервные клетки. В кардиомиоцитах развиваются явления миокардиодистрофии с последующим их некрозом, миолизом и развитием инфекционно-токсического миокардита. Поражение капилляров при дифтерии сопровождается инфекционно-токсическим шоком. Повреждение нервных клеток сопровождается дистрофическими изменениями швановских клеток и демиэлинизацией нервных волокон. Наряду с отмеченным, общее действие дифтерийного токсина проявляется явлениями общей интоксикации. Таким образом, дифтерийный гистотоксин оказывает местное и общее воздействие на организм

Классификация дифтерии Дифтерия ротоглотки Дифтерия носоглотки Дифтерия носа Дифтерия дыхательных путей (дифтерийный круп) Дифтерия кожи Редкие формы: дифтерия глаза, дифтерия гениталий, дифтерия наружного слухового прохода, дифтерия пищевода и желудка. Бактерионосительство. Носительство возникает у лиц, имеющих даже высокий уровень антитоксического иммунитета. 16

Дифтерия ротоглотки При дифтерии зева пленки располагаются на миндалинах, небных дужках и других участках мягкого неба. Пленки тесно спаяны с некротизированным плоским эпителием, при их отделении появляются капли крови - «кровяная роса».

Дифтерия кожи «Шея Цезаря»

Иммунитет После перенесенного заболевания формируется стойкий антитоксический иммунитет – вырабатываются антитоксические антитела Основная роль в профилактике дифтерии принадлежит формированию активного искусственного антитоксического иммунитета в результате плановой вакцинации

Эпидемиология Источник – больной или бактерионоситель Входные ворота инфекции – слизистые оболочки ротоглотки, носоглотки, слизистая оболочка глаза, кожа, в редких случаях местом локализации может быть наружный слуховой проход, слизистая наружных половых органов, пищевод и желудок. В подавляющем большинстве случаев входными воротами является слизистая оболочка ротоглотки и носоглотки, поэтому ведущим механизмом передачи является воздушно-капельный. Учитывая другие входные ворота инфекции возможен и контактно-бытовой механизм передачи. Для эпидемий дифтерии характерны периодические подъемы каждые -7 лет Заболеваемость повышается в осенне-зимний период

Действующее начало всех вакцин – дифтерийный анатоксин (дифтерийный гистотоксин, утративший токсичность,но сохранивший антигенные свойства в результате обработки формалином при 37-40С в течение 3 недель: АД – адсорбированный дифтерийный анатоксин АДС – адсорбированный дифтерийно-столбнячный анатоксин АДС-М анатоксин -вакцина для профилактики дифтерии и столбняка с уменьшенным содержанием антигенов АД-М анатоксин вакцина для профилактики дифтерии с уменьшенным содержанием антигенов Имовакс Д.Т. Адюльт вакцина для профилактики дифтерии и столбняка, аналог АДС-М (Aventis Pasteur, Франция) ДТ Вакс вакцина для профилактики дифтерии и столбняка, аналог АДС (Aventis Pasteur, Франция) Специфическая профилактика

Специфическая профилактика ТетрАкт-ХИБ Адсорбированная вакцина против дифтерии, столбняка, коклюша и гемофильной инфекции типа b (Франция) Тританрикс вакцина для профилактики коклюша, дифтерии, столбняка и гепатита В ( СмитКляйн Бичем, Бельгия) Тетракок 05 вакцина для профилактики коклюша, дифтерии, столбняка и полиомиелита (Aventis Pasteur, Франция) Инфанрикс бесклеточная вакцина для профилактики коклюша, дифтерии и столбняка (Бельгия) Пентаксим Вакцина для профилактики дифтерии и столбняка адсорбированная, коклюша ацеллюлярная, полиомиелита инактивированная, инфекции, вызываемой Haemophilus influenzae тип b конъюгированная. АКДС – адсорбированная коклюшно-дифтерийно-столбнячная вакцина

Лечение Нейтрализация токсина путем введения противодифтерийной сыворотки антитоксической (донорской или лошадиной) Антибиотикотерапия: пенициллины, цефалоспорины, хинолоны и др. Лечение
Лабораторная диагностика дифтерии Клинический материал: мазок из зева, слизь из носоглотки и др. Методы: Бактериоскопический (окраска мазка поЛеффлеру и Нейссеру – предварительный) Бактериологический (культуральный) - основной Серологический (ИФА, латексагглютинация, реакция нейтрализации антител, РНГА) для обнаружения антител и/или токсина в сыворотке крови ПЦР Проба Шика – реакция нейтрализации токсина in vivo

Бактериологический метод 1 этап: посев клинического материала на кровяной теллуритовый агар (среда Клауберга). 2 этап: Макроскопическое изучение колоний, мазок по Леффлеру или Неййсеру; отсев типичной колонии на среды Ру или Леффоера 3 этап: Идентификация по совокупности свойств: культуральных, морфологических, тинкториальных, биохимических, обязательно определение токсигенности методом Оухтерлони; чувствительности к антибиотикам.

26 Схема бактериологической диагностики дифтерии

Двойная диффузия в геле по Оухтерлони ( может проводиться без выделения чистой культуры) Тест Элека и его модифицированные варианты

Биохимическая диагностическая тест-система НПО «Диагностические системы» (г.Нижний Новгород) Проба Пизу (цистиназа)

Проба Шика проводится для оценки состояния антитоксического иммунитета; внутрикожно вводят минимальное количество токсина: При наличии антител против дифтерийного токсина видимых изменений не будет При отсутствии антитоксического имммунитета наблюдается воспалительная реакция
60-difteriya.ppt
- Количество слайдов: 29

